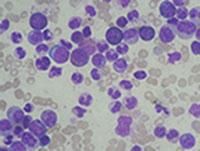

This topic takes on average 25 minutes to read.
There are a number of interactive features in this resource:
 Chemistry
Chemistry
 Biology
Biology
 Human biology
Human biology
 PSHE / Citizenship studies
PSHE / Citizenship studies
The body can develop many harmless lumps. They are generally not a sign of cancer but it is always best to get them checked by a doctor.
Lumps that are not cancers are called benign. They are harmless but may still be removed by surgery, if they are causing discomfort or there is a chance they could develop into a cancer.
Lumps that are cancers are called malignant. These need to be detected and treated as early as possible. Quick treatment gives the best chance of a successful treatment.
Leukaemia is a cancer that can affect young children as well as adults. It is a cancer of the white blood cells. There are different types of leukaemia depending on which type of white blood cell is growing out of control.
Symptoms of leukaemia can include:
Having just one of these symptoms does not mean that the person has leukaemia. Having several of them could point to leukaemia. Further tests are needed to definitely diagnose the condition.
Compare the results of blood tests in the chart below to see how a sample can be used to detect leukaemia. Blood cells are made in the bone marrow, so doctors may also analyse a sample of tissue (biopsy) taken using a needle into the bone marrow.
| Normal range | Chronic Myelogenous Leukaemia (CML) | |
|---|---|---|
| White blood cells per mm3 | 4 - 10,000 | 100,00+ |
| Haemoglobin (grammes per litre) | 12 - 18 | less than 8 |
| Platelets per mm3 | 150,000 - 450,000 | 100,000 |
Blood smear examined under a microscope:
|
 |
|
The medicines used to treat the different types of leukaemia may vary but treatments can include:
As with any cancer, the earlier the treatment is started, the better the chance of recovery. Two common childhood leukaemias are Acute Lymphoblastic Leukaemia (ALL) and Acute Myeloid Leukaemia (AML). Treatments for these cancers continue to improve and the graph shows the percentage of children alive five years after being diagnosed with leukaemia. These children are highly likely to be completely cured.
